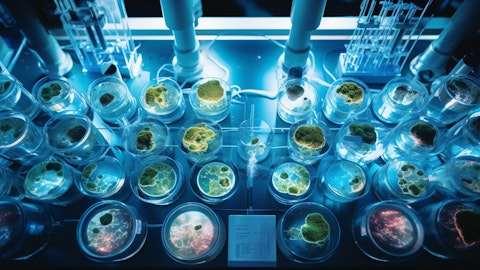

Fulgent Genetics, Inc. (NASDAQ:FLGT) Q3 2024 Earnings Call Transcript November 11, 2024
Operator: Greetings and welcome to the Fulgent Genetics Q3 2024 Conference Call and Webcast. At this time, all participants are in a listen-only mode. [Operator Instructions] A question-and-answer session will follow the formal presentation. [Operator Instructions] As a reminder, this conference is being recorded. It’s now my pleasure to turn the call over to your host, Melanie Solomon, Investor Relations. Please go ahead.
Melanie Solomon: Good morning and welcome to the Fulgent third quarter 2024 financial results conference call. On the call today are Ming Hsieh, Chief Executive Officer; Paul Kim, Chief Financial Officer; and Brandon Perthuis, Chief Commercial Officer. The company’s press release discussing the financial results is available on the Investor Relations section of the company’s website, fulgentgenetics.com. A replay of this call will be available shortly after the call concludes on the Investor Relations section of the company’s website. Management’s prepared remarks and answers to your questions on today’s call will contain forward-looking statements. These forward-looking statements represent management’s estimates based on current views, expectations and assumptions, which may prove to be incorrect.
As a result, matters discussed in any forward-looking statements are subject to risks, uncertainties and changes in circumstances that may cause actual results to differ from those described in the forward-looking statements. The company assumes no obligation to update any of the forward-looking statements it may make today to reflect actual results or changes in expectations. Listeners should not rely on any forward-looking statements as predictions of future events and should listen to management’s remarks today with the understanding that actual events, including the company’s actual future results, may be materially different than what is prescribed in or implied by these forward-looking statements. Please review the more detailed discussions related to these forward-looking statements, including the discussions of some of the risk factors that may cause results to differ from those described in the forward-looking statements contained in the company’s filings with the Securities and Exchange Commission, including the previously filed 10-K for the year-ended December 31, 2023 and subsequently filed reports, which are available on the company’s Investor Relations website.
Management’s prepared remarks, including discussions of earnings and earnings per share, contain financial measures not prepared in accordance with accounting principles generally accepted in the United States, or GAAP. Management has presented these non-GAAP financial measures because it believes they may be useful to investors for various reasons, but these measures should not be viewed as a substitute for or superior to the company’s financial results prepared in accordance with GAAP. Please see the company’s press release discussing its financial results for the third quarter 2024 for more information, including a description of how the company calculates non-GAAP income or loss, earnings or loss per share, non-GAAP gross profit, non-GAAP gross margin, non-GAAP operating profit or loss and margin, and adjusted EBITDA, and a reconciliation of these financial measures to income or loss, earnings or loss per share, and operating margin to the most directly comparable GAAP financial measures.
With that, I’d now like to turn the call over to Ming.
Ming Hsieh: Thank you, Melanie. Good morning and thank you for joining our call today. I will start with some comments on the third quarter and our two business lines, then Brandon will review our product and go-to-market updates for our laboratory services business in the third quarter, and Paul will conclude with the financials and the outlook before we take your questions. We are pleased with our results in the third quarter with $71.7 million of total revenue. Third quarter revenue of $71.7 million was driven by our momentum in precision diagnostics, particularly preproductive health and oncology. We were pleased with our growth from the second to the third quarter of 2024 in all three areas of our laboratory services business this quarter, and we see good momentum ahead as we continue to invest in reproductive health, testing see benefit of those investments.
In our therapeutic development business, this year, we initiated a Phase II clinical trial of FID-007 in combination with cetuximab in patients with HNSCC and enrolment began in the second quarter. So far, we have dosed eight patients in this trial and are encouraging preliminary results from this initial patient. We expect to enroll approximately 40 patients at various sites and to complete enrolment in early 2026. We continue to estimate the total patient clinical trial cost of the Phase II trial to be approximately $10 million. We continue to advance our second drug candidate, FID-022, nanoencapsulation FM38 in preclinical study towards and investigational new drug application at the end of this year. While we have observed FID-022 has shown superior efficacy over [indiscernible] in various xenographic models, including COVID, [indiscernible] ovarian pancreatic cancers in our preclinical studies.
No significant unexpected toxicities were observed in both [indiscernible] GLP toxicity studies. In addition, we also made a significant advancement in the development of antibody drug conjugate using our novel patient linker and payload platform technology. In preclinical studies, we observed our ADV will have better efficacy over different tumors with a broad range of target antigens expression level compared with some of the best ADC benchmarks on the market in preclinical set. In the meantime, ADC to novel target using our novel platform technology are also being prepared with the goal of generating leading candidates for our clinical studies. As a remember, all our drug candidates were founded with our novel nanoencapsulation technology, which includes over 30 issued of active patents and active patent applications and targeted therapeutic platform designed to improve therapeutic windows for pharmacokinetics and existing cancers.
Overall, we believe we have a good strategy with our core laboratory services business and our therapeutic development business. We see momentum in our core business which we believe will continue to grow potentially strengthening our business model and fueling our therapeutic initiatives. We continue to maintain a strong balance sheet, which will execute our strategy. I would like to thank our employees, partners and stakeholders for your hard work and loyalty in a very good third quarter for our business. We hope to have a strong close to the year. Now I turn the call over to Brandon Perthuis, our Chief Financial Officer, to talk more about the power of our laboratory services business results in the third quarter. Brandon?
Brandon Perthuis: Thank you, Ming. It was another solid quarter for our company with quarter-over-quarter growth in all three areas: precision diagnostics, anatomic pathology, and pharma services. This marked the second quarter in a row where we have seen growth in all three areas of our laboratory service business. I’ll provide some highlights for each. For precision diagnostics, we continue to see strength in reproductive health. Our Deacon expanded carrier screening test continues to be in high demand and we are leveraging our excellent turnaround time, quality and flexibility to drive business. We are also seeing strength in hereditary cancer screening. We recently announced a new contract with the VA hospitals for hereditary cancer and other germline tests.
This contract is up to $99 million over five years. This was a very competitive process and we are honored that the VA chose to work with Fulgent. We believe the VA selected Fulgent based on our rapid turnaround time, ability to build custom panels, our quality and our strength for IT integrations. A quick update on KNOVA, our novel NIPT test. Our sales team is now fully trained and began selling in September of this year. The feedback from clients has been positive as they see the value of adding de novo point mutations to aneuploidy and microdeletions. We expect adoption to be a bit slow as we look to replace testing that has been in place for a very long time; however, we believe KNOVA has the potential to create a paradigm shift in NIPT considering the increased detection rates of severe conditions.

Turning to our oncology offering, we were excited to receive MoIDX approval for many of our hereditary cancer panels during the quarter. This adds to our portfolio of MoIDX approved cancer tests, which includes our liquid biopsy test, solid tumor panel, gene panel, and now several hereditary panels. Looking at precision diagnostics overall, we saw an increase in revenue of 18.8% year-over-year. Moving over to anatomic pathology, we believe our investments here are really beginning to pay off. For a few quarters, we definitely had some headwinds; however, we kept our heads down and remained focused and dedicated to improving this business. We are pleased with the progress we are making in this business as a result of a larger improved sales team, a major focus on lab turnaround time and improved logistics, among other things.
These areas of focus are leading to the sales team closing new deals. From what we can tell, there is strain on many other labs as it relates to turnaround time, specifically some labs are delivering derm path turnaround time of two to three weeks. We are typically at two or three days. Add to this the quality we deliver with our sub-specialty trained pathologists and we have a very compelling offering for physicians. This has led to a deep pipeline of opportunities which we believe will continue to fuel growth. We mentioned on the last call that we have moved into our new building in Coppell, Texas. During the quarter, we saw this operation run at scale and it is impressive. We believe the improved design and workflows are leading to a more efficient, scalable laboratory.
One other thing worth mentioning is our increased adoption of digital pathology. For the third quarter, overall we digitized 80% of our slides. We believe this leads to improved operational efficiency, quality, and in the future the ability to layer on AI. Turning to our biopharma services division. As we have mentioned in previous calls, we are now able to leverage a large portfolio of tests, which are in demand from biopharma clients. In addition to Illumina next-generation sequencing, we have now validated the platforms from 10x Genomics, Akoya, Olink and Mission Bio. This larger service offering has increased our addressable market, allowing us to potentially compete for additional requests for proposals. This area of our business does have the longest sales cycle and these wins can come in waves, so we do expect to see some variability quarter-to-quarter.
However, we are enthusiastic about the long-term potential for our biopharma services division. Overall, it was a solid quarter and we are thankful for the dedication of our employees. We believe we are taking the right steps to set Fulgent up for continued growth and long-term success. I’ll now turn the call over to Paul Kim, our Chief Financial Officer. Paul?
Paul Kim: Thank you, Brandon. Revenue in the third quarter of 2024 totaled $71.7 million compared to $84.7 million in the third quarter of 2023. Revenue from COVID-19 testing is negligible this quarter. Revenue from our core business totaled $71.7 million. GAAP gross margin was 37.3% and on a non-GAAP basis was 40%. Gross margins continue to improve year-over-year, showing the benefit of our continued efficiencies and streamlining of our business. Total GAAP operating expenses were $43.9 million for the third quarter compared to $45.4 million in the second quarter of 2024, primarily related to reversal of legal accrual and lower R&D spend in Q3. Non-GAAP operating expenses totaled $32.9 million compared to $33.8 million in the second quarter of 2024.
Non-GAAP operating margin increased approximately 2 percentage points sequentially to minus 6%, primarily due to higher revenue, reversal of legal accrual, and lower R&D spend in Q3. In the third quarter, the company recorded a $10.1 million impairment of available for sale debt securities, which negatively impacted EPS by 33%. This is a non-cash charge and relates to the company’s July 2021 investment in Helio Health, a private company, which gave the company access to emerging liquid biopsy testing technology. Our projections for the performance of this investment have weakened, leading management to recognize an impairment loss. This impairment reflects management’s assessment of the future cash flows associated with this investment.
Adjusted EBITDA income for the third quarter was approximately $400,000 compared to an income of $18.1 million in the third quarter of 2023. On a non-GAAP basis and excluding equity-based compensation expense, intangible asset amortization and impairment of available for sale debt securities, income for the quarter was $9.4 million or $0.31 per share, based on 30.7 million weighted average fully diluted shares outstanding. Turning to the balance sheet. We ended the quarter with approximately $815.4 million in cash, cash equivalents, restricted cash and marketable securities. Cash used in the period included $24.6 million for income tax credits purchased and $11.1 million for the purchase of the building and property in our Alpharetta, Georgia lab is located, which is partially offset by cash from other operating activities.
Moving onto guidance. We’re reiterating our revenue outlook for 2024 and improving our EPS guidance, as outlined in our press release issued today. With minimal future revenue from COVID-19 testing expected, we are guiding to core revenue, which is total laboratory services revenues for the company without COVID-19 testing revenue. We continue to expect total core revenue to be approximately $280 million for 2024, representing core growth of 7% year-over-year. Turning to expected margins for 2024, excluding COVID-19 revenue and stock-based compensation, we expect non-GAAP gross margins for the full year to be in the high 30% range and exiting the last quarter around our target of 40%, which we saw in both Q2 and Q3. We expect to see slightly lower non-GAAP operating margin in the fourth quarter as we further invest resources to grow our business, with operating margin of approximately minus 12% for the year.
We remain focused on managing our spend and continue to believe that our foundational technology platform supports a strong margin profile long-term. We continue to expect associated cash burn for our therapeutics development business of about $15 million to $17 million this year, which is contemplated in our EPS and cash guidance. We expect to see improvement in our GAAP EPS loss from $1.95 to approximately $1.70 per share, excluding any future one-time charges, using a 30 million average share count. Utilizing a non-GAAP tax provision and average share count of $30 million, we currently expect full year 2024 to improve from a net non-GAAP loss of $0.30 per share to a net non-GAAP income of $0.33 per share for our shareholders, excluding stock-based compensation, impairment of available for sale debt securities, and amortization of intangible assets, as well as any one-time charges.
Finally, our cash position remains strong. As mentioned earlier, the company purchased investment tax credits in the third quarter of 2024. The company expects to receive an income tax refund from the federal government of $27.1 million in Q4 of 2024 as a result of the purchase of those tax credits. Excluding any stock repurchases or other expenditures outside the ordinary course, which could include M&A, we anticipate ending 2024 with approximately $800 million of cash, cash equivalents, investments and marketable securities. Overall, we see strength in our core business, which has grown organically through strategic acquisitions, and we see good momentum ahead. Thank you for joining our call today. Operator, now you may open it up for questions.
Operator: Certainly. We will now be conducting a question-and-answer session. [Operator instructions] Our first question is coming from Dan Leonard from UBS. Your line is now live.
Q&A Session
Follow Fulgent Genetics Inc. (NASDAQ:FLGT)
Follow Fulgent Genetics Inc. (NASDAQ:FLGT)
Receive real-time insider trading and news alerts
Li Lu: Great, thank you. Good morning. This is Lu on for Dan. Thank you for taking my questions. I guess like first thing, definitely great momentum in precision diagnostics and the AP business, two quarters of growth. Wondering how do you think about the trends in the next 12 months?
Brandon Perthuis: The trends in the next 12 months?
Li Lu: Yes, just like how do you think about like going into 2025?
Brandon Perthuis: Well, as we mentioned on the call, we certainly see momentum. The business we have in precision diagnostics, as well as anatomic pathology is sticky business, it’s long-term business, so we see that as a foundation to grow on, but our position in both of those markets continues to strengthen. We continue to deliver excellent turnaround time, quality, ease of use. I think we’re continuing to strengthen both of those areas. So I think the momentum continues for the next 12 months. The pipelines across both AP as well as precision diagnostics have some significant opportunities in them. I believe sales leadership and the sales team are all executing, so I think we’re going to exit this quarter and exit 2024 with good momentum heading into next year.
Li Lu: Great. And then talking about the VA contract, it’s $99 million over five years. Should we think about like any kind of big contribution in ’25, or is it just simply divided by five? And then also in terms of the pipeline of that kind of contract, do you see anything that will coming up in the next 12 months as well?
Brandon Perthuis: A good question, and thank you for the question. Probably not fair to just divide by five, I mean, it takes some time to scale these types of contracts. So I think each year will probably be a little bit more than the previous. It’s our sales team’s responsibility to connect with these hospitals, to set these hospitals up as accounts, to get them our portal access, to get them supplies. We have to get them to a point where they can order these tests that does take some time. But we do think it will contribute meaningfully in 2025, and we are very proud to have won that award. There are very good labs out there offering hereditary cancer tests, and that opportunity with the VA was a big one, a prestigious one. It was highly competitive and Fulgent Genetics won it. So we’re very pleased that they chose us. We look forward to serving the VA, and I think we’re going to do a great job for them and be a great long-term partner for the VA.
Li Lu: Got it. Switching to the OpEx line, so SG&A roughly flat sequentially, but R&D is – I mean, also sequentially declined. I’m wondering like what were the changes in the quarter, and then also, I guess, like maybe you also mentioned the gross margin kind of in around 40%, – like 40% in Q4. I’m wondering is that a jumping off point for ’25 as well?
Paul Kim: Yes. So I will address the question about the gross margins, the SG&A, and then I’ll touch on the R&D spend and I’ll turn it over to Ming, who can talk about our development efforts. The gross margins, we’re actually very, very pleased with the progress that we’ve seen in the gross margins, particularly over the past couple of years. We achieved, excluding stock-based compensation, 40% now two quarters in a row. I think based on what we’re seeing, Q4 should be at least that. We’re targeting 40%, we’re hopeful that it can potentially be higher than that. And as we look out to 2025 and the expansion of our business’ continued automation and efficiencies, we like where our gross margins are heading. As far as the OpEx and the SG&A, for this particular quarter, we had a few things happen for the upside, meaning less spending.
As you have probably seen over the past several quarters, we have been having some reversal of prior bad debt reserves, which has favorably impacted G&A. We also had this quarter a reversal of some legal accruals which made that G&A number be even more favorable. Having that said, I think on a going forward basis, excluding stock-based compensation, the G&A line should be roughly between $19 million and $20 million. If you actually include stock-based compensation, it should be between $22 million and $23 million. So I think as we close out the year and look out into 2025, that’s probably a better number for G&A. And then as far as the spending on R&D, that tends to fluctuate based on what we have happening during our programs. On the one hand, we are okay with the R&D spend being where it is, but on the flipside, we also are very cognizant that development efforts and our focus in that area is tied to the future of the company from a technology perspective.
So I’ll turn it over to Ming, who can make some comments about our development efforts, both on the diagnostics as well as on the therapeutic side.
Ming Hsieh: Yes. Thank you, Paul. [Technical Difficulty] continue to invest in new technology in the diagnostics side, continue to develop new tests and continue to receive the MoIDX from those new tests initiative. On the pharma side, we are ramping up in terms of our clinical trials, as well as the new drug target [Technical Difficulty] trials. As Paul mentioned, we start to see some [Technical Difficulty], but in general our R&D cost is going to be increased as we have more products and more drugs moving into clinical trials.
Li Lu: Got it. Appreciate it. Very helpful.
Ming Hsieh: Thank you.
Operator: Thank you. The next question is coming from David Westenberg from Piper Sandler. Your line is now live.
David Westenberg: Hi, thanks for taking my question. You mentioned all three business segments in lab contributed to growth. Can you remind us about the strategy change you had in anatomic pathology. It does seem like it’s working. Do you see this as completely fixed? And then as we think about that business on a go-forward basis, how should we think about growth? It’s still a more mature market, so I would guess it would be below company rates.
Brandon Perthuis: Yes, thank you for the question. First and foremost, I’d like to acknowledge and thank our laboratory and our pathologists. Our sub-specialty trained pathologists in our lab, they’re fantastic. Our turnaround times are great, our quality is great, our relationship with our clients are great. So first and foremost, a lot of the credit goes to the operations, the pathologists and our staff. That quality has allowed our sales team to go out there and represent a fantastic laboratory, so we’re out there finding clinicians, whether it’s derm, GI, GU, that are having pain points with their existing labs, and sometimes that’s quality, often it’s turnaround time. We mentioned on the call we’ve done very well in derm path.
We run into a lot of clients out there that are getting two or three-week turnaround time for dermatology services. We’re at two or three days right now, and that’s really important in all aspects of service, but especially in pathology. So we’ve mentioned before we have a slightly larger sales team. We’ve brought in some very experienced people, some very good people. We’ve also brought in some additional sales leadership to complement the existing good leadership we have, so I believe we do have a world-class sales team now for that organization. We did also revamp how we compensate our sales team. When we acquired the company, we felt like there was too much emphasis on account management and too much incentive pay weighted to account management.
The sales team needs to go out there and drive new business, we need to find new clients. So we did completely overhaul that comp plan and we heavily weighted it for new business compensation. So that happened in January, and that team has calibrated their activities to not just focus on account management, but instead go out there and hunt new business. They’re doing that. We’ve had back-to-back-to-back great quarters for that line of business. The pipeline is as strong today as it ever has been. And I think on a monthly basis, we can continue to set new volume records since we acquired that business, so we’re pretty optimistic and I think it’s going to carry into 2025.
David Westenberg: Got it. And then I just want to — Ming, go ahead?
Ming Hsieh: Sorry. Adding onto Brandon’s comments, I think the technology enhancement does play a significant role. We are getting close beyond the 80% of fully digitization in terms of all our dermatology or pathology slides, we are pushing for the 100% towards the year-end. With the digitization and the enhancement of our work through and include AI technology or implants in-house, we do see the efficiency and data increases our pathologist efficiency, and as well as the quality. So we’re proud of our technology enhancement and in collaboration with Brandon’s sales team effort, so we do see a very good growth path for the business.
David Westenberg: Got it. Thank you very much. And then just in terms of — I’m going to go to the OpEx and maybe get Paul involved here. Is there any additional OpEx associated with the VA contract that we should expect before, say, the revenue hit? Just trying to kind of think about the way you’re going to be preparing for that. And then also in the OpEx questions, how should we think about the capital expenses you made on the Texas facility this year on other parts in the OpEx, like I’m guessing that’s going to be maybe fixed costs that can help you with some of the stuff associated with the gross margin improvement, or things like that. Thank you, and maybe some – yes, G&A in the lab.
Paul Kim: Yes, thank you for the question. So on the VA, the answer is no. We have all the capabilities, including the people to service that contract, so we should be able to see accretiveness run through as that contract kicks in. And then as far as the CapEx and the usage of our new Texas facility, we purchased that in cash. We’re very happy that we own that facility. That facility is fully up and running, staffed by extremely capable people. We also took a look at our entire organization to see how much leverage we can get out of that facility. I’ll turn it over to Brandon, who can make some additional comments as to our intentions, as well as our usage of that facility.
Brandon Perthuis: Yes, I don’t have a whole lot to add. I’ll just say it’s a big testament to our team. We relocated that lab, the entire lab – all the equipment, all the people, everything and had almost zero disruption in turnaround time, so I think it just shows how strong we are in that operation. In addition, we do have some space there to continue to expand. I mentioned in the quarter that it was running at scale, and it actually gave us — by moving it, it actually gave us an opportunity to design it from the ground-up, and not a lot of pathology labs, because a lot of them have been around a long time, have the opportunity to build it from scratch. So we were there, and just seeing the flow, the operation, the efficiency, the scalability, it is an impressive operation, so it will support our growth in AP. But in addition, we do have some space should we decide to build out further capabilities in the future, which we’re talking about.
David Westenberg: And then just the last one, and I don’t know if you guys disclosed this, but I think it might be in the Qs. Just in terms of end market by payer, are you doing a lot of stuff inpatient versus outpatient and or running a lab as a provider for other labs? If you can give us kind of a breakdown of that, and there’s two things I’m trying to get at with that. Generally speaking, I mean, like there has not been as many true-ups with your business versus what we’re seeing with Guardant and Tempus and all of the other ones that are getting a lot of those billing from prior quarters. But then I also just want to get your sense for as some of these payors, there may be some expectations in the coming years that they’re going to be a little bit more conservative with payouts potentially, so I just want to know about your exposure in some of those, and that will be my last question. Thank you.
Brandon Perthuis: Yes, it’s a good question. Thank you for the question. So we have a diversified business here, first and foremost, and meaning we’re not entirely reliant on third-party, we’re not entirely reliant on CMS and Medicare reimbursement. We have institutional business from hospitals, we have commercial pay insurance, we do have government pay, we have partnerships like the VA, for example. We have B2B relationships, we have direct-to-consumer relationships through our platform, so we are a diversified business. And I think the question you have to ask with a little more granularity, because it’s really test-driven, right?- I mean, if you’re a company that’s offering a novel test that insurance hasn’t really picked up on reimbursement yet, so if it’s investigational, experimental, unproven, your life becomes a little more difficult in terms of reimbursement.
But a lot of the things that we’re offering are pretty much standard of care these days, reimbursement is pretty solid, and again, we’re not entirely reliant on reimbursement. So, I think in terms of our collectability, the quality of revenue, so to speak, what we can collect on what we run has been pretty good. Did I answer your question? We may have lost David.
David Westenberg: No, I’m on, I’m on. That was the last of my questions, so I thought I was — that was the end. Thank you so much.
Brandon Perthuis: Yes, thank you.
Operator: Thank you. The next question is coming from Andrew Cooper from Raymond James. Your line is now live.
Andrew Cooper: Hey, everyone, thanks for the question. Maybe just first, a lot going on in the space over the last week or so in general, so any change or any opportunities you see with M&A occurring in particular that you could call out. And then I also want to talk about just recent coverage decision or changing coverage for pharmacogenomics that felt like an area you were highlighting a little bit in the VA announcement, that that was included, so just would love to hear sort of how you think about that space and if there’s anything that’s changed since that announcement with United’s decision not to cover.
Brandon Perthuis: Yes, thanks for the question, Andrew. In terms of PGX in the VA, it’s a cash paid opportunity, essentially. So we have almost no exposure to reimbursement as it relates to PGX. So obviously, PGX is an important test for us. I mean, it provides a lot of value in terms of patient care, precision medicine, but it’s also not a super high volume test for us historically. But we’re happy to partner with the VA, right, that’s a great opportunity for us to expand our PGX offering, but it’s not relying on third-party reimbursement, if that makes sense.
Andrew Cooper: Okay.
Brandon Perthuis: And I’m sorry, the first part of the question was…
Andrew Cooper: M&A, just the [indiscernible] so far any change there.s
Brandon Perthuis: Yes, there is no M&A we would like to call out, as you said. But this entire management team spends a lot of time evaluating M&A, nearly on a daily basis. As we’ve mentioned on the call, we’re pretty happy with our cash position, somewhere north of $800 million, so we have the optionality there to do M&A. And for us, we’re just being careful, we’re being cautious. We’ve done M&A so far and it’s worked well for us, so I think we’ve proven we can identify the right targets. We’ve proven we can integrate those assets and proven we can improve those assets, so we know we can make it work, but we need to find the right target. So nothing to call out yet, but certainly high on the priority list at the company.
Andrew Cooper: Sorry, I actually meant for M&A — that’s helpful, but I actually meant is there any potential disruption to others, where you could pick up share if the landscape changes at all competitively with Ambry under the broader Tempus umbrella at this point, as they try to build up a little bit more fulsome of an offering.
Brandon Perthuis: Yes, I’ve got you. Look, I don’t think we want to comment too much on that acquisition. I mean, I don’t think it affects us too much either. So I mean, we’re more focused on what we’re doing here than kind of what’s going on with some other companies. And I just don’t think that’s going to affect how we operate here at the company, and we’ll just leave it at that.
Andrew Cooper: Okay, helpful. And maybe just one last one on the VA contract again. Just want to be clear, so the up to [$99 million] [ph], I mean, are we thinking about this right to think it’s really kind of a hunting license now for you to go to these VA clinicians and say, “Hey, we are something you’re able to order, have sort of reimbursement and an established relationship, but it is incumbent on you to go create that volume that maybe is easier with the contract than without, or just how do we think about that? And maybe if you could give us a sense, how much revenue were you generating from the VA prior to this news, and is this entirely incremental to that or perhaps a little bit of it is growth along with that?
Brandon Perthuis: Yes, you nailed it. It is a hunting license, and you said is it easier now than it was. Well, it’s possible now, right? I mean, it would not be possible without this $99 million contract. So now that we have it, our sales team can call on those hospitals, get them set up in our system, get them the recs, the kits, and get them ordering, so yes, it is a hunting license. I mentioned on the call that we think it will take some time to scale that. It’s not necessarily $99 million divided by five, it will take some time to scale it. But it is a hunting license that now makes that possible. It was not possible for us to sell hereditary cancer into the VA without that contract. So very happy to get that contract and really happy with the team that made that happen.
It is all incremental to our VA. We don’t break out clients by revenue, but I can represent to you that it is all incremental and it’s significantly incremental overall to the business, we think in 2025. We do think we’re going to capture a significant amount of the contract starting next year.
Andrew Cooper: Perfect. I’ll stop there. Thanks.
Operator: Thank you. We’ve reached the end of our question-and-answer session. And ladies and gentlemen, that does conclude today’s teleconference and webcast. You may disconnect your lines at this time and have a wonderful day. We thank you for your participation today.
Follow Fulgent Genetics Inc. (NASDAQ:FLGT)
Follow Fulgent Genetics Inc. (NASDAQ:FLGT)
Receive real-time insider trading and news alerts